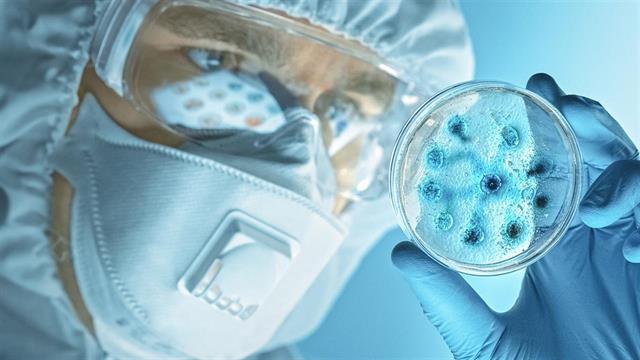
Υπό ανάπτυξη συνθετικά αντιβιοτικά - Μπορούν να σώσουν εκατομμύρια ζωές

Επιστήμονες του University of Liverpool προχώρησαν ένα βήμα μπροστά όσον αφορά το να ξεκλειδώσουν τη δυνατότητα για νέα κατηγορία ισχυρών αντιβιοτικών, ικανών να σκοτώνουν ισχυρούς ιούς όπως ο MRSA χωρίς αντίσταση.
Οι ερευνητές ανέπτυξαν απλοποιημένες συνθετικές εκδοχές του μορίου teixobactin, που χρησιμοποιείται από βακτήρια για την εξουδετέρωση άλλων βακτηρίων στο έδαφος.
Ανέπτυξαν και δοκίμασαν μοναδική βιβλιοθήκη συνθετικών εκδοχών του αντιβιοτικού, βελτιστοποιώντας χαρακτηριστικά του φαρμάκου για την ενίσχυση της αποτελεσματικότητας και ασφάλειας, ενώ επιτρέπει την παραγωγή του με χαμηλό κόστος.
Επικεφαλής της έρευνας είναι ο δρ Ishwar Singh. Η ερευνητική ομάδα απέδειξε ότι απλοποιημένα συνθετικά teixobactins εξουδετερώνουν ευρεία γκάμα βακτηρίων που ελήφθησαν από ασθενείς, όπου τα υπάρχοντα αντιβιοτικά αποτυγχάνουν.
Οι ερευνητές πέτυχαν επίσης να εξολοθρεύσουν με επιτυχία τον MRSA σε ποντικούς και φάνηκε να συσσωρεύονται σε περιοχές λοίμωξης έως 24 ώρες, σε μεγαλύτερες ποσότητες από αυτές που χρειάζονται για να εξουδετερωθούν ισχυροί ιοί. Αυτό υποδεικνύει ότι στο μέλλον ασθενείς ενδεχομένως μπορεί να αντιμετωπίζονται με μια δόση teixobactin την ημέρα για συστημικές απειλητικές λοιμώξεις.
Τα συνθετικά teixobactins φάνηκε να είναι ισχυρά και σταθερά σε θερμοκρασία δωματίου για χρόνια.
Προσθέστε το iatronet.gr στο DiscoverΕιδήσεις υγείας σήμερα
Μπορούν τρόφιμα να ενισχύσουν την απορρόφηση της βιταμίνης D;
Ημέρα του Πατέρα: Διατροφικές επιλογές για καλύτερη υγεία
Πρωινές συνήθειες που βοηθούν στη δυσκοιλιότητα
Πιο αποτελεσματική η αντιμετώπιση των ανθεκτικών μικροβίων με τη σωστή σειρά των αντιβιοτικών
Πιο αποτελεσματική η αντιμετώπιση των ανθεκτικών μικροβίων με τη σωστή σειρά των αντιβιοτικών Μικροβιακή αντοχή: Μία πανδημία σε αργή κίνηση που μπορούμε να αποτρέψουμε
Μικροβιακή αντοχή: Μία πανδημία σε αργή κίνηση που μπορούμε να αποτρέψουμε Οι μεγαλύτεροι ''μαγνήτες'' μικροβίων
Οι μεγαλύτεροι ''μαγνήτες'' μικροβίων Η ΕΕ επενδύει 30 εκατομμύρια ευρώ για την καταπολέμηση της μικροβιακής αντοχής
Η ΕΕ επενδύει 30 εκατομμύρια ευρώ για την καταπολέμηση της μικροβιακής αντοχής Μικρόβια σε όγκους επηρεάζουν την αποτελεσματικότητα των θεραπειών
Μικρόβια σε όγκους επηρεάζουν την αποτελεσματικότητα των θεραπειών Τεστ ανάλυσης μικροβιώματος: Πού, πώς και γιατί να το κάνω
Τεστ ανάλυσης μικροβιώματος: Πού, πώς και γιατί να το κάνω Μπορούν τρόφιμα να ενισχύσουν την απορρόφηση της βιταμίνης D;
Μπορούν τρόφιμα να ενισχύσουν την απορρόφηση της βιταμίνης D; Ημέρα του Πατέρα: Διατροφικές επιλογές για καλύτερη υγεία
Ημέρα του Πατέρα: Διατροφικές επιλογές για καλύτερη υγεία Πρωινές συνήθειες που βοηθούν στη δυσκοιλιότητα
Πρωινές συνήθειες που βοηθούν στη δυσκοιλιότητα Βρώμη και κινόα: Πώς συγκρίνονται από άποψη πρωτεΐνης
Βρώμη και κινόα: Πώς συγκρίνονται από άποψη πρωτεΐνης Ρύζι, πατάτες και ζυμαρικά: Ποιο είναι χειρότερο για το σάκχαρο;
Ρύζι, πατάτες και ζυμαρικά: Ποιο είναι χειρότερο για το σάκχαρο; Με ποιες τροφές να συνδυάζω ρύζι, πατάτες και ζυμαρικά για να μην αυξάνεται απότομα το σάκχαρο
Με ποιες τροφές να συνδυάζω ρύζι, πατάτες και ζυμαρικά για να μην αυξάνεται απότομα το σάκχαρο Pharmathen: Βαθιά κρίση και μηδενισμός αποτίμησης από funds της Partners
Pharmathen: Βαθιά κρίση και μηδενισμός αποτίμησης από funds της Partners Καρπούζι: Ποια είναι τα οφέλη του στην υγεία
Καρπούζι: Ποια είναι τα οφέλη του στην υγεία Ισχυρή πρωτιά της ΔΗΚΙ στις εκλογές του Ιατρικού Συλλόγου Αθηνών - Ρεκόρ συμμετοχής
Ισχυρή πρωτιά της ΔΗΚΙ στις εκλογές του Ιατρικού Συλλόγου Αθηνών - Ρεκόρ συμμετοχής Ιατρικός Σύλλογος Θεσσαλονίκης: Σαρωτική επικράτηση της ΕΝΟ.ΣΥ. - Ν.Ι.Κ.Ι.
Ιατρικός Σύλλογος Θεσσαλονίκης: Σαρωτική επικράτηση της ΕΝΟ.ΣΥ. - Ν.Ι.Κ.Ι. Φαρμακοβιομηχανίες σκέφτονται να χτυπήσουν την πόρτα της Εθνικής Αρχής Διαφάνειας
Φαρμακοβιομηχανίες σκέφτονται να χτυπήσουν την πόρτα της Εθνικής Αρχής Διαφάνειας Οι απρόσμενες συνέπειες της ολοκληρωτικής παράλειψης της ζάχαρης από τη διατροφή [μελέτη]
Οι απρόσμενες συνέπειες της ολοκληρωτικής παράλειψης της ζάχαρης από τη διατροφή [μελέτη]